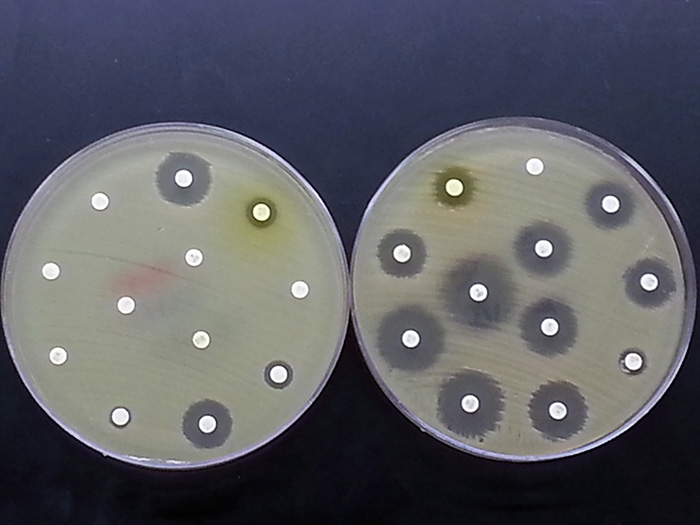

Resistant E. coli rises despite drop in ciprofloxacin use
Community circulation of ciprofloxacin-resistant E. coli paradoxically increased after six-year reduction in antibiotic prescriptions.Media Contact: Leila Gray - 206-475-9809, leilag@uw.edu

After a nearly threefold drop in prescriptions for the antibiotic ciprofloxacin between 2015 and 2021, the rates of ciprofloxacin-resistant E. coli bacteria circulating in the community did not decline.
In fact, a study of Seattle-area women over age 50 who had not taken any antibiotics for at least a year discovered that the incidence of gut-colonizing ciprofloxacin-resistant E. coli actually increased. About 1 in 5 women in the study were affected.

Scientists at the University of Washington School of Medicine, Kaiser Permanente Washington Health Research Institute and Seattle Children’s Hospital conducted the study. Their findings appear in Communications Medicine, a new, open-access Nature Portfolio journal.
Their results are consistent with theoretical models indicating that, once a drug-resistant form of E.coli emerges, it will continue to spread by taking up long-term residence in individuals’ gut microbiomes. E. coli is among an alarming number of disease-causing bacteria that have become resistant to several types of antibiotics. Resistance means that the antibiotics can’t kill the bacteria.
Pathogenic E. coli from the gut occasionally enters the urinary tract opening and causes infections. The female pelvic anatomy makes women more vulnerable to these mobile bacteria. Postmenopausal women are especially susceptible to severe, drug-resistant infection. Some drug-resistant E. coli infections are associated with considerable risk of hospitalization and death from sepsis.
Urinary tract infections from antibiotic-resistant E. coli can be frustrating to treat, even with third-generation cephalosporins, the newer types of antibiotics that are being prescribed more frequently for some populations of patients. Resistance to cephalosporins among ciprofloxacin-resistant E. coli also rose between 2015 and 2021.
Ciprofloxacin and similar drugs in its class were once the most prescribed antibiotic for urinary tract infections. In 2015, recommendations from the Centers for Disease Control and Prevention, Food and Drug Administration and Infectious Disease Society of America discouraged broad use of this class of drugs for uncomplicated urinary tract infections, partly due to rising resistance.
“However, it appears to be questionable whether a reduction in antibiotic use can be effective in reducing the rates of resistance in E. coli infections,” the research paper’s authors noted.
“Evidence from studies such as this one may be changing lots of paradigms on how to fight the rise in antibiotic resistance,” said physician scientist Dr. Evgeni V. Sokurenko, professor of microbiology at the University of Washington School of Medicine, who headed this latest research.
In the study, the scientists examined participants’ positive samples to determine which antibiotic-resistant strains of E. coli were present.
They found that the rate of a particularly virulent strain, ST1193, rose during the study period. Together with E. coli strain ST131-H30, these strains are the major causes of a global pandemic of multi-drug-resistant urinary tract infections among all women.

If ST1193 makes its home in more people’s guts, the situation could lead to more urinary tract infections with this more virulent strain, regardless of the curbing of fluoroquinolones prescriptions.
Another strain with a troubling increase in the participant samples was ST69, known to more frequently cause urinary tract infections in children.
The study findings suggest that scientists should prioritize discovering better ways to control drug-resistant E. coli’s ability to colonize the gut before it causes these infections, the authors wrote. They mentioned potential strategies of deploying probiotic bacteria and anti-bacterial viruses (bacteriophages).
The researchers added that these approaches might be offered to high-risk patients or deployed against the most clinically relevant strains. More investigation is needed on the epidemiology and ecology of antibiotic-resistant gut E. coli, they said, to help determine how these bacteria skillfully colonize human guts and how to target them most effectively to reduce antibiotic-resistant infections.
Dr. Veronica L. Tchesnokova, research scientist in microbiology in the Sokurenko lab at the UW School of Medicine, was lead author on the paper. The UW Medicine and Seattle Children’s Hospital team worked with Dr. James Ralston and others at Kaiser Permanente Washington Health Research Institute.
Grants from the National Institute for Allergy and Infectious Diseases at the National Institutes of Health (R01AI106007 and R01AI150152) supported this work.
For details about UW Medicine, please our About page.